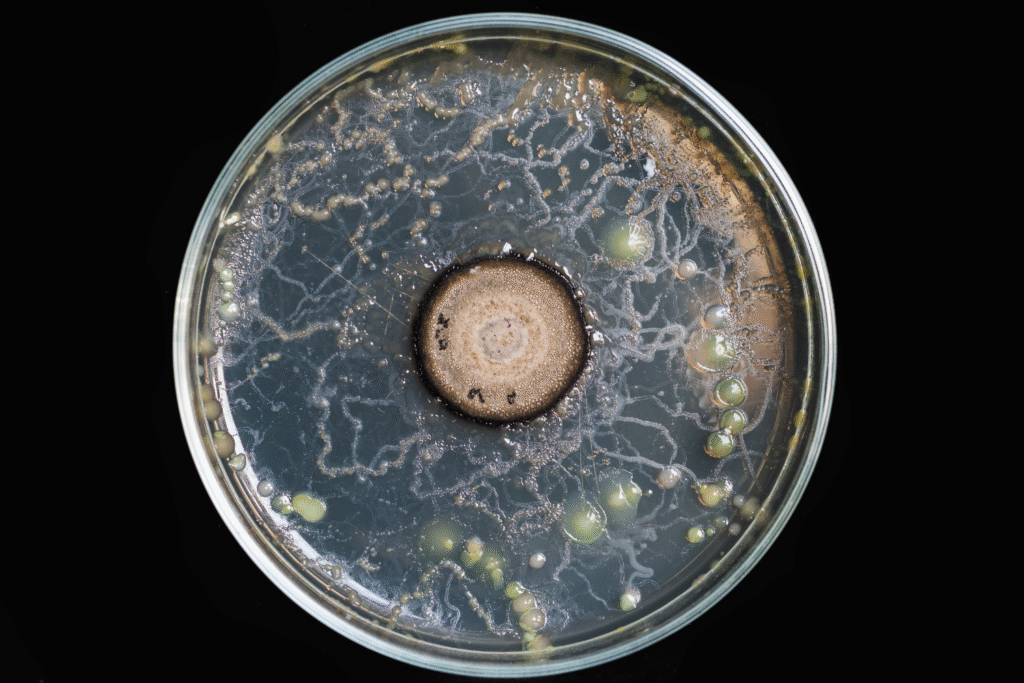

The planet’s earliest balance may not have been accidental.

Long before animals stirred or plants reshaped the land, Earth moved through a vast stretch of time guided by something rarely credited with power. Evidence now suggests that this presence did more than survive early chaos. It altered chemistry, stabilized systems, and quietly prepared the planet for what came next.
For nearly a billion years, it may have shaped soil, atmosphere, and possibility itself, without leaving monuments or obvious traces. Only recently have scientists begun to see the outline of this influence. If the findings hold, the story of how Earth became livable starts far earlier, and with a ruler almost no one was watching.
1. Fossils reveal fungi thrived long before plants existed.

Researchers examining ancient Canadian rock deposits found fossilized fungal filaments dating back nearly a billion years. These microscopic remains showed that fungi were living and growing on land at a time when Earth’s continents were still barren of plants. Their presence marks them as some of the earliest colonizers of land, carving out a niche where no green life yet existed, as discovered by scientists studying the Grassy Bay Formation in 2019. That discovery reframed how we picture early Earth—wet, rocky, and covered in mats of fungal life instead of greenery.
2. Fungi slowly turned stone into fertile soil.

Bare rock offers little comfort to life, but fungi knew how to change that. Their filaments crept into mineral cracks, releasing acids that dissolved rock, a process that slowly created the planet’s first soils. That transformation opened the way for plants to eventually take root. This isn’t speculation but documented through geochemical studies of ancient minerals, which show fungal breakdown long before roots were around, according to a 2021 report in Nature Geoscience. Without that patient work, the stage for future forests and farms would have never been set.
3. DNA research shows fungi’s deep evolutionary roots.
Molecular studies comparing fungal genes to those of other life forms suggest their lineage diverged from animals more than a billion years ago. What’s striking is that this timing matches the fossil record hinting that fungi were already adapting to land long before plant partners appeared. This convergence of fossil evidence with gene sequencing has strengthened the case that fungi not only preceded plants but actively paved the way, as reported by evolutionary biologists in Proceedings of the Royal Society. Fungi’s ancient DNA essentially preserved a map of life’s earliest experiments.
4. Their underground networks shaped entire landscapes.

As fungal mats spread, they formed thick weblike networks across ancient terrain. These networks not only stabilized fragile soils but also trapped water and nutrients, creating microhabitats for other early microbes. Their growth essentially stitched together the loose threads of Earth’s surface, preventing constant erosion and making the land more habitable. Think of them as the original architects of ecosystems, long before forests rose into view.
5. Fungi prepared the stage for photosynthesis on land.

When plants eventually appeared, they found themselves stepping into a world already sculpted by fungi. The soils were loosened, nutrients were available, and fungi were waiting to form partnerships. Without this groundwork, plants may have struggled to gain a foothold on continents. Their eventual spread wasn’t a sudden conquest but rather a cooperative takeover with fungi as the quiet hosts of the land.
6. Early fungi partnered with algae in strange forms.

Before plants, fungi often linked up with algae in what we now call lichens. These partnerships acted like miniature ecosystems, capable of drawing energy from sunlight and nutrients from rock. Lichens could colonize surfaces no other organisms could handle, covering bare stone and slowly breaking it down further. That collaboration likely played a crucial role in making more complex terrestrial life possible later on.
7. Ancient fungal forests towered across barren landscapes.

Long before trees filled Earth’s skyline, enormous fungi called Prototaxites rose up, some nearly 30 feet tall. For millions of years, these towering organisms dominated landscapes in ways we can hardly imagine today. Scientists once thought they were trees or seaweed, but evidence confirmed they were giant fungi. They shaped the carbon cycle of their time and offered shade and structure in ecosystems otherwise dominated by microbes.
8. Their role in global carbon cycles was unmatched.

Fungi didn’t just make soil; they locked and released carbon at massive scales. By breaking down rock and organic matter, they influenced atmospheric carbon dioxide levels. That process helped stabilize Earth’s climate during periods when temperatures could have swung wildly. Their presence was not just local but global, with cascading effects on oceans, air, and the chemistry of life itself.
9. Mycorrhizal partnerships anchored plant success stories.

When plants finally appeared, fungi wasted no time linking roots into their underground networks. These mycorrhizal partnerships remain one of biology’s most successful collaborations, with plants trading sugars for water and nutrients provided by fungi. That deal was forged hundreds of millions of years ago, but it rests on a billion-year head start fungi had in mastering land environments.
10. Fungi were resilient through Earth’s harshest climates.

Over that billion-year reign, Earth cycled through ice ages, volcanic upheavals, and shifting continents. Fungi endured them all, adapting to conditions that wiped out countless other forms of life. Their resilience meant that ecosystems had a steady anchor, even as the environment transformed again and again. They weren’t just survivors but steady engineers through chaos.
11. The hidden legacy of fungi lingers in every forest.

Today’s forests owe much of their richness to fungi’s ancient groundwork. The loamy soil, the underground webs linking trees, and the delicate balance of nutrients all trace back to that deep history. When you walk in a forest now, you’re stepping across land first built by fungal pioneers. That invisible legacy is still working beneath your feet.
12. Their billion-year reign still shapes modern science.

Fungi are more than relics of deep time. Their enzymes inspire new medicines, their networks are studied as models of communication, and their ability to reshape environments is still being applied in agriculture and conservation. That billion-year head start is not just ancient history—it’s a continuing blueprint for how life can adapt, endure, and transform a planet. Scientists keep uncovering new ways fungi quietly shaped our world, and they still have more to teach us.
